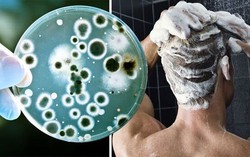
Bác sĩ cảnh báo: Không vệ sinh thứ này trong phòng tắm đúng cách có thể gây tổn thương da, phổi

TAG vi khuẩn trong phòng tắm
Bác sĩ cảnh báo: Không vệ sinh thứ này trong phòng tắm đúng cách có thể gây tổn thương da, phổi
Phòng & chữa bệnh 19:24 26/08/2023Bác sĩ cảnh báo, việc giữ phòng tắm sạch sẽ có ý nghĩa vô cùng quan trọng với sức khỏe của bạn.
